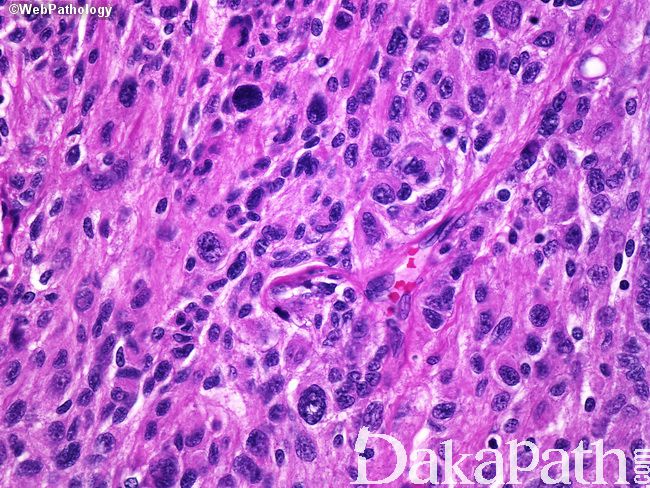

脑膜瘤
Meningioma
概述:
来自脑膜上皮细胞的肿瘤,常位于硬脑膜,可见 WHO I、II (不典型)或 III (间变型)。
发病部位: 颅内最常见于大脑镰部、大脑凸面、嗅沟、蝶骨嵴、鞍结节及蝶鞍旁区,亦可见于脑室内、松果体区、颅后窝及椎管内等。
诊断要点:
常见,占原发性颅内肿瘤的 30%,发病高峰位于 65-75 岁,男女发病之比约 1:2,临床表现根据病变累及的部位而定。
大体特点:多数境界清楚,具有薄层包膜,或分叶哑铃状,不典型及间变型常黏附于脑部组织(微囊型除外),纤维型表面光滑。微囊型常黏附于水肿脑组织,有时可被包埋其中。邻近颅骨常增厚伴或无肿瘤浸润,矢状窦旁肿瘤可伴上矢状窦的浸润;
组织学特点:
(1)脑膜上皮亚型:细胞叶状分布,胞浆丰富及胞界不清(合胞体样),核内假包涵体,胞核均匀浅灰色;
(2)纤维型:梭形细胞簇状分布,不定程度的胶原及网状蛋白成分,线状间质钙化;
(3)过渡型:可见混合性脑膜上皮及纤维性结构,常见漩涡状及砂砾体;
(4)砂砾体型:可见大量砂砾体,部分出现少量脑膜上皮细胞;
(5)血管瘤型:可见大量血管,大的厚壁血管类似血管畸形,小血管类似血管母细胞瘤;
(6)微囊型:常见与脑组织黏附,细胞之间质地疏松,局灶或经典脑膜瘤样区域,可见泡沫细胞,核多形性及散在细胞,类似血管母细胞瘤,出现增厚血管玻璃样变;
(7)分泌型:脑膜上皮细胞中可见假砂砾体,小的嗜酸性球体,有时单细胞中可见多个;
(8)富于淋巴浆细胞型:伴大量慢性炎症,可见浆细胞伴 Russell 小体;
(9) 化生型:无单一组织学类型,可见脂肪瘤样、黄色瘤样、软骨样、黏液样或骨样,脂肪瘤样类似正常脂肪组织;
(10)脊索瘤型(WHO II 级):上皮样、脊索瘤样形成,脊索瘤样比例要求没有统一的定论,常与普通脑膜瘤相关;
(11)透明细胞型(WHO II 级):细胞呈单形性,胞浆透亮、PAS 阳性及富于糖原,少数或见旋涡状,无砂砾小体或核包涵体;
(12)横纹肌样型(WHO III 级):可见偏心性胞核及显著核仁,嗜酸性胞浆核旁漩涡状,Ki67 标记指数偏高,常与普通脑膜瘤相关,无不典型性及核分裂;
(13) 乳头状型(WHO III 级):可见血管周围假菊形团形成,常与不典型脑膜成分相关,有时与横纹肌样结构相关。
(14)少数组织学类型可见嗜酸细胞型(颗粒状胞浆、富于线粒体)、脑膜瘤伴脑膜血管瘤病、上皮样(索状或小叶状结构类似腺样分化,分泌性亚型)。
其他相关特点,可见没有意义的血管浸润(硬脑膜窦常见,尤其是上矢状窦),系统性转移(III 级为主,肺部转移常见,其他部位包括肝脏、淋巴结及骨)。
根据核分裂分级,I 级:≤ 3 个核分裂/10HPF; II 级:≥4 个核分裂/10HPF ;III 级:≥ 20 个核分裂/10HPF。

免疫组织化学染色:
Nestine、Claudin1 阳性,EMA 胞膜常阳性,局灶或弱阳性。约 2/3 病例 CK18 阳性,CK20 阴性,其他 CK 不同程度及局灶阳性。CEA 分泌亚型假砂砾小体及周围阳性。PR 不同比例阳性,阴性亦不能排除脑膜瘤,间变型仅少数阳性。ER 常阴性。S100 胞浆胞核阳性。D2-40 及 E-cadherin 均阳性。Somatostatin receptor type IIA(SSTR2A)胞浆胞膜阳性。
鉴别诊断:
脑膜上皮增生 :邻近出血、炎症可促进上皮增生,呈小的脑膜上皮细胞肿块样病变。
神经鞘瘤 :状结构及棒状胞核,S100(+)、EMA(-)及 SSTR2A(-),细胞周围的胶原 IV 型及网状蛋白阳性。
脊索瘤 :中线分布,可见骨破坏及空泡细胞,Brachyury (+)、keratin (+)及 EMA(+),S100 阳性及阴性。
血管母细胞瘤 :无漩涡状及砂砾小体,网状亚型可见广泛网状蛋白,间质细胞 Inhibin-α 阳性,少数 EMA 阳性。
黑色素细胞瘤 :巢状结构及不同程度黑色素,HMB-45(+)、Melan-A(+)、S100(+)及 SOX10(+),EMA(-)。
脑膜血管瘤病 :皮质内斑块样,大量内陷的脑组织伴神经节细胞,血管周围脑膜上皮及梭形细胞,部分与脑膜瘤相关。
孤立性纤维性肿瘤 /:血管外皮瘤富于网状蛋白,孤立性纤维性肿瘤梭形细胞之间条索状胶原,无钙化及砂粒体,CD34 的 SPF 弥漫阳性,而 HPC 阳性或阴性,EMA 阴性,STAT 6 核阳性。
转移性癌 :CK 强阳性。
Rosai-Dorfman 病 :大的组织细胞 S100 阳性,可见伸入运动。
脑膜纤维肉瘤 :梭形单形性,鱼骨样结构,细胞外大量网状蛋白阳性,EMA 阴性。
肥胖细胞性星形细胞瘤 :脑实质内浸润性生长,神经丝状背景,血管周围慢性炎症,GFAP 阳性。
星形细胞瘤 :脑实质内,常呈囊性,血管玻璃样变,GFAP 阳性,局灶 EMA 阳性。
血管畸形 :非肿瘤性脑膜上皮细胞。
浅表胶质母细胞瘤/胶质肉瘤 :可见 GFAP 阳性,肉瘤成分细胞周围大量网状蛋白,EMA 阴性(除了上皮成分分化)。
← 化生性脑膜瘤 脑膜孤立性纤维性肿瘤 →
